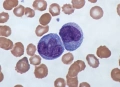
Азур - еосин по Романовски 99 % прах - багрило за микроскопско наблюдение., снимка 1

simov
В Bazar.BG от 30 януари 2010г.
Последно активен
вчера в 11:56 ч.
Азур - еосин по Романовски 99 % прах - багрило за микроскопско наблюдение. → Обява 53505320
Азур - еосин по Романовски 99 % прах - багрило за микроскопско наблюдение.
Състояние
Ново
Доставка
Купувача
Оцветяването по Романовски е прототипна техника за оцветяване, която е предшественик на няколко различни, но подобни оцветители, широко използвани в хематологията (изследване на кръвта) и цитопатологията (изследване на болни клетки).
Оцветителите от типа Романовски се използват за диференциране на клетки за микроскопско изследване в патологични проби, особено кръвни и костномозъчни филми и за откриване на паразити като малария в кръвта.
Цена - 2 евро/гр. и куриерски
Преглеждания: 71
Другите търсят също
Вход
Регистрация
Влез в профила си или се регистрирай, за да не губиш наблюдаваните обяви, търсенията си и следваните потребители – ще ги имаш навсякъде с теб.
Вход/Регистрация